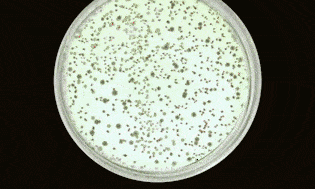
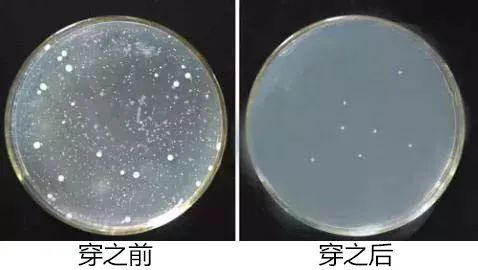

女人们都盼着疫情早点结束
能早点出门逛街,跳广场舞
可一捏肚子竟然肥了那么多肉肉
羞于见人了!

疫情期间在家吃吃喝喝
这腰真和个水桶没区别
捏一捏都要抖三抖,哭~

臭男人嘴上说“老婆你再胖我都爱你”
可私底下却总偷瞄那些小腰精们
想想也正常
美好的东西谁不想多看两眼
难道对着粗腰肥臀来性致?
这次复工
惊讶发现公司最胖的阿文竟然没发福
腰围还变瘦了一圈!
我惊呼 “ 你绑瘦身带了?”
阿文说 “谁绑那玩意
又闷又热,扣子又多!”

接着她凑过来,神秘一笑
“是一条能减肥的内裤!”
她压低了声音接着说
“穿了它,连我那个病都好了不少。”
↓↓↓
【咖啡因高腰提臀收腹裤】


它强力包裹住整个腰腹部
全天燃脂瘦身
惊喜的是还能抑菌消炎
淡化恼人的女性炎症!
穿3个月,小蛮腰出来了!
▽▽▽

小肚子肉眼可见的消失了!
▽▽▽

从此告别收腹带,一条内裤就能瘦身!
▽▽▽

燃脂收腹,腰部秒瘦3寸!
还杀灭妇科细菌!
第二条半价!

内裤+塑身
一步到位
肥胖女性会选择厚重的收腹裤
或者绑收腹带,瘦是瘦了
但夏天闷热无比
扣子多上厕所又不方便

这条内裤
一次性结合塑身瘦腰+内裤的功能
不管多大的肚子
一秒就吃掉了
无需额外多绑塑腰带

1秒提臀
瞬间还你小蛮腰!
肉眼直观显瘦10-15斤!

腰腹侧还有2根合金记忆鱼骨
加紧固定住脂肪
瞬间强力秒收小肚子

以前拉不上的拉链
如今一下子拉上了
根本不需要再多穿什么塑身衣!


高度到达胃部
将胸部以下的赘肉一网打尽
利用“赘肉可流动性”原理
将流失、位移、下垂的赘肉
回归到正确的位置并加以锁定
垂直定位

穿久了
腰部的肉不但少了
还会回归到正确的位置
不再下垂变松
一条内裤轻松穿出小蛮腰~

燃脂收腹,腰部秒瘦3寸!
还杀灭妇科细菌!
第二条半价!

“咖啡因”疯狂燃脂
一秒“吃掉”小肚子
整块腹部采用一种神奇的咖啡因面料
这是一种最天然的”减肥利器”
能燃烧溶解掉脂肪细胞
消除赘肉、塑造S体型

穿着后
面料纤维里包裹的“咖啡因微囊纤维”
立即被体温激活
能迅速渗透到腰臀腿等部位
直接燃烧细胞、溶解脂肪颗粒
脂肪厚的硬的
会慢一点
脂肪松弛的会快一点
很多粉丝穿了一个月不到
就瘦了三四斤
腰围少了四五公分


此外咖啡因还能促进宿便排出
加快肠胃蠕动
让无用、多余的“废物毒素”
迅速排出体外
达到美体瘦身效果

小肚子一天比一天平坦
凸出的赘肉渐渐消失不见了
别人都以为你吃了减肥药
其实只是穿对了内裤而已
这款塑身内裤不只是
把咖啡因涂在面料表面
而是做成微型胶囊融入面料组织纤维中
清洗三百次咖啡因才会开始减少
坚持穿,很快就能看到效果

这款塑身衣的设计
处处都充满惊喜
在腹部竟还有两个4个鼓起来的火山能量石

它环布在腹部和宫区
能加快燃脂的速度
激活细胞的营养吸收
当细胞吃饱时
就会快速排出毒素
腰腹部的新陈代谢回到了年轻
让你瘦个不停

穿一天=消耗10个汉堡热量
臀围、腰围一天天减少
真正做到不运动就能瘦下来
懒人的终极梦想!


普通内裤穿一个月就裆部发黄
上面沾满无数霉菌真菌
特别有炎症的女性
容易造成反复交叉感染
这条瘦身内裤它
采用碳素纤维为底档
这是一种抑菌性极好的高科技面料
洗涤100次后杀菌率仍达99%

碳素纤维作为一种高科技面料
能发射远红外的热效应
温升1-3℃
从而促进血液循环
裆部强力消炎抑菌
亲眼见证一下实验
看看它如何点亮灯泡
用碳素纤维做成的底档
能杀灭金黄色葡萄球菌
大肠杆菌,霉菌等真菌
能预防女性妇科炎症加重
防止细菌遗留在内裤上形成交叉感染

一整天下来内裤依然清爽洁净
杜绝了裆部的细菌繁殖后再与私处接触
自然也就阻断了妇科病来源
不少粉丝反映分泌物减少了
异味也减轻了

燃脂收腹,腰部秒瘦3寸!
还杀灭妇科细菌!
第二条半价!

亚洲女性很少有翘臀
特别生完孩子后首先臀部扁塌
盆骨变宽
穿裤子裙子时
一点曲线感都没有

这款塑身裤采用
W型动力学原理
就像两只手举托住臀部
防止臀部下垂、走形
一穿立刻显出“小翘臀”提高臀线

特别适合肥胖妈妈们
或者产后恢复
坚持穿着能够让臀型更加自然
臀线有效提高1-2cm

瘦身裤的轮廓有着完美的张力
长期穿着
还能360°矫正变形松垮的骨盆
让你腹壁上多余移位的赘肉恢复如初

只要长期穿它
什么大妈臀
平板臀都滚一边去吧
咱们也能拥有诱人的蜜桃臀~


普通的棉内裤
洗几次就变形松垮
还越洗越大
穿3个月就得扔

这款瘦身裤采用亲肤面料
技术人员亲测穿200次都
不发皱,不松垮
触感绵柔像云朵一样
包裹时却紧致有力道

有着双重弹力
面料的自身弹力+腰腹部增加针织密度
所以哪怕穿个三两年
收腹力和弹力依旧强劲

先进的全无缝车线工艺
一体成型、没有多余线头
不会磨损肌肤
更不会留下难看的勒痕

已同步到看一看
写下你的想法
前往“发现”-“看一看”浏览“朋友在看”